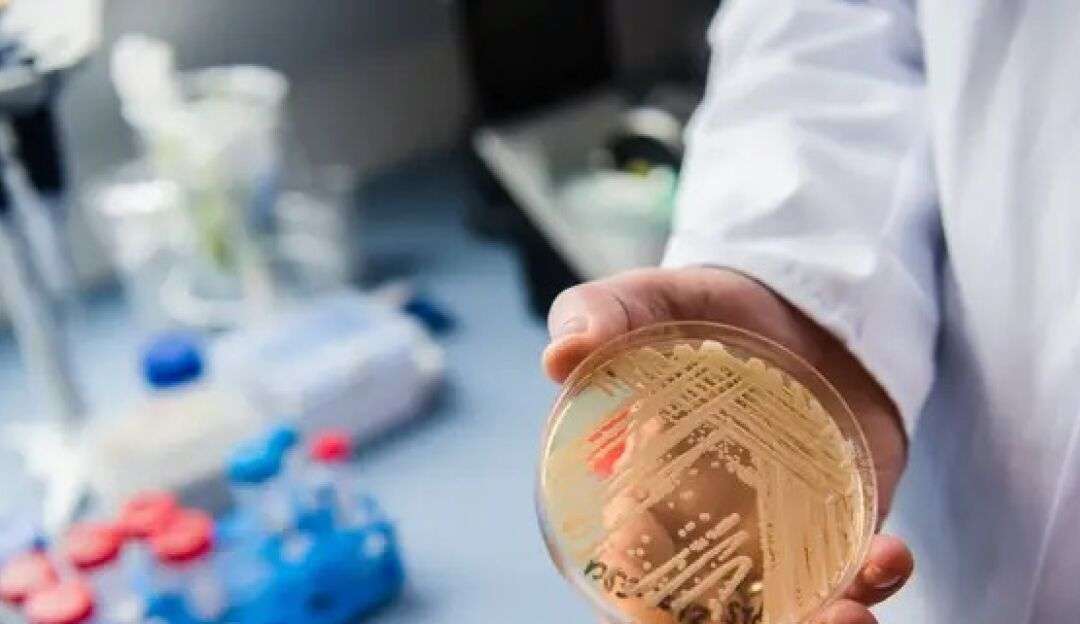

Candida auris: Sobe para nove o número de casos em Pernambuco
Sobe para nove o número de casos confirmados de contaminação pelo fungo Candida auris. Os novos casos foram confirmados em Pernambuco, em homens de 50 e 54 anos.
No estado de Pernambuco foram apresentados dois novos casos do fungo Candida auris. A Secretaria Estadual de Saúde (SES-PE) relatou que os dois pacientes são homens, de 50 e 54 anos.

Fungo Candida auris (Foto: Reprodução/BBC)
O Candida auris é um “superfungo” que se mostrou uma séria ameaça à saúde devido à capacidade do microrganismo de resistir à potentes medicamentos antifúngicos.
O primeiro caso de Candida auris no Brasil foi relatado em novembro de 2020, em um homem de 59 anos, que estava internado em Salvador, na Bahia. O fungo foi detectado após análise do Laboratório do Hospital das Clínicas de São Paulo e pelo Laboratório Central de Saúde Pública Prof. Gonçalo Moniz (Lacen/BA).
A Secretaria Estadual de Saúde (SES-PE) informou que os dois homens que foram confirmados com o fungo estão internados no Hospital do Tricentenário, em Olinda. Atualmente, dos nove casos confirmados para Candida auris no ano de 2023, cinco deles são de pacientes do Hospital do Tricentenário, segundo a secretaria.
Com isso, o número de casos sobe para nove no ano de 2023. Os pacientes entraram no hospital apresentando outras queixas de saúde, como infecção do trato urinário e sequelas de acidente vascular cerebral (AVC) e não mostraram manifestações clínicas devidas da infecção pelo fungo.
Os diagnósticos foram executados após a realização de exames de vigilância para casos com relação a pessoas que já tiveram o diagnóstico confirmado.
Na sexta-feira (02), a direção do Hospital Miguel Arraes (HMA) e a Secretaria Estadual de Saúde deram início ao processo de desbloqueio dos leitos da unidade. O desbloqueio será feito gradativamente. Até o momento, 56 leitos foram liberados, constando 28 de cirurgia geral e mais 28 de ortopedia. Esses leitos serão destinados para receber pacientes encaminhados pela Central Estadual de Regulação de Leitos. Até o momento, o setor de emergência está sem receber novos pacientes.
Foto destaque: O fungo Candida auris. Reprodução/BBC










